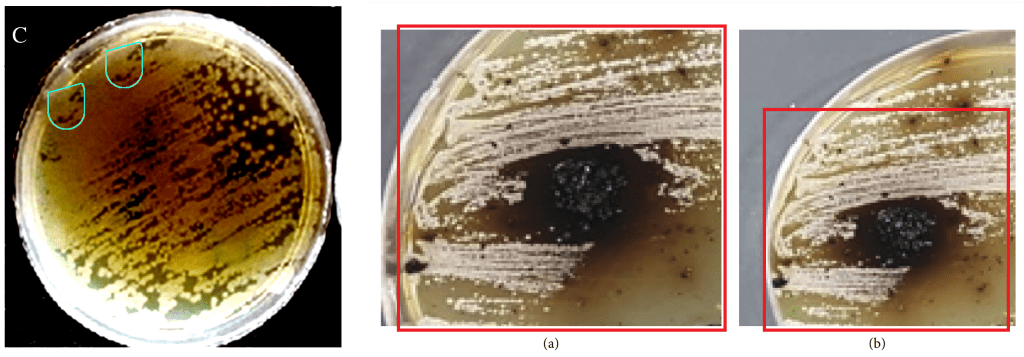

Smut Clyde, for reasons which may or may not be related to beer, decided to revisit the case of Iranian chemistry faker aptly named Ali Fakhri, and I found myself unable or unwilling to stop him. This time, you will meet Fakhri’s collaborator Mosstafa Kazemi and a lot of other characters, some real, some imaginary, and some possibly both. They all publish in a journal-shaped thingy called Synthetic Communications. Rafael Luque and Changhe Li will fly by, and just when you’ll think the wretched tale is finally over – there is a coda about Afshin Davarpanah.
Settle down with a beverage of your choice, and let the fraud wash over you.

Ali Fakhri: The unavoidable disappointing sequel

By Smut Clyde
We previously encountered Ali Fakhri as an exponent of what was then an unfamiliar notion: that someone could fabricate line-graphs – spectra and X-ray diffraction distributions – as a change from Western Blots and microphotographs as the usual expressions of forgery. That post also introduced S. Sudheer Khan and his oeuvre, to make up the word-count, although Khan’s work skewed more toward skull-juggling and other confections of make-believe electron-microscopy.


But more entertainment awaits! As well as revisiting Dr Fakhri, we will meet the artificial messages of Synthetic Communications (“An International Journal for Rapid Communication of Synthetic Organic Chemistry”) and some of the synthesised individuals who communicate there. All seem to be associates of one Mosstafa Kazemi. There is also Afshin Davarpanah. Which is to say, in this post I am working Alexander Magazinov’s side of the street, to dwell on sordid topics like citation-farming / extortion and the international fellowship of Highly-Cited Researchers. But all that in its turn.
Nanodandruff and synthetic spectroscopy
The story of two data fabricators and Elsevier regulars, Sudheer Khan and Ali Fakhri. Smut Clyde brings them together in this new guest post about nanotechnology
It came as no surprise that Dr Fakhri’s academic advancement was not impeded in the least by the number of PubPeer threads celebrating his creativity – none of which provoked retractions.1 Though his workshop is of the digital photo- form, a cavalcade of freshly-synthesised nanomaterials continues to spill out of it, each with unmatched properties of catalysing the breakdown of some problematic pollutant. Complaisant Elsevier editors continue to publish his announcements. I made a spreadsheet.
Nanomaterials call out for illustrations, as tokens of all the research gone into characterising their properties. So here are some old and new Fakhrified XRDs, with spikes and stretches of baseline noise shuffled into new permutations.


Fig 1 from “Synthesis and characterization of MnS2/reduced graphene oxide nanohybrids for with photocatalytic and antibacterial activity” (Fakhri & Kahi 2017).
Rght: Fig 1 from “Sonocatalytic, sonophotocatalytic and photocatalytic degradation of morphine using molybdenum trioxide and molybdenum disulfide nanoparticles photocatalyst” (Agarwal et al 2017).

Fig 1 from “Iron doped SnO2/Co3O4 nanocomposites synthesized by sol-gel and precipitation method for metronidazole antibiotic degradation” (Agarwal et al 2017)
These are electron-spin resonance spectra, apparently; unless they are a lot of M letters written in a row by someone practicing their joined-up cursive penmanship. Inspiration may have come from Amit Kumar.

Epileptic spasms of tics and glitches in Krautrock diffractograms
Smut Clyde chases free radicals in a German-run lab in China
Call me old-fashioned, but I am not a fan of time functions that double back on themselves.

“A strategy of silver Ferrite/Bismuth ferrite nano-hybrids synthesis for synergetic white-light photocatalysis, antibacterial systems and peroxidase-like activity” (Mao et al 2022}
“Fabrication of CuMoS decorated WO nano heterojunction embedded on chitosan: Robust photocatalytic efficiency, antibacterial performance, and bacteria detection by peroxidase activity” (Lin et al 2022)
“Did the authors wonder why efficiency and capacity both loop back to the beginning of a long repetition, after ~300 cycles?”
“”Fig. 5. The photoluminescence spectra for un-doped (a), 6 (b) and 10 mol% (c) Cu doped Ag2S nanoparticles.” I have marked some repetitive regions.’
ImageTwin found some purloined TEMs.

Right: (CdO) 0.40 (ZnO) 0.60 NPs from “Down-top nanofabrication of binary (CdO)x (ZnO)1–x nanoparticles and their antibacterial activity” (Al-Hada et al 2017).
“Synthesis and optical characterization of copper oxide nanoparticles” (Lanje et al 2010) was published by Pelagia Research Library: a low-profile and unambitious imprint that at some point was absorbed into or had its identity stolen by the OMICS scampire. Its obscurity was no defense against Fakhri’s depredations, and its Figures were plundered for two of his papers.

“Assessment of Ethidium bromide and Ethidium monoazide bromide removal from aqueous matrices by adsorption on cupric oxide nanoparticles” (Fakhri 2014).
ImageTwin informs me that Fig 1b of “Matrix Structure Evolution and Nanoreinforcement Distribution in Mechanically Milled and Spark Plasma Sintered Al-SiC Nanocomposites” (Saheb et al 2014) was repurposed to become
- Fig 2B of “Microwave-Assisted Synthesis of SiC Nanoparticles for the Efficient Adsorptive Removal of Nitroimidazole Antibiotics from Aqueous Solution” (Fakhri et al 2017).
- Fig 4B of “Optimization of toxic biological compound adsorption from aqueous solution onto Silicon and Silicon carbide nanoparticles through response surface methodology” (Gupta et al 2017).

When you’re set up to falsify the meta-data stripes for SEMs, the possibilities are endless. The chitosan nanoparticles featured in from “Water-Soluble Chitosan Nanoparticles Inhibit Hypercholesterolemia Induced by Feeding a High-Fat Diet in Male Sprague-Dawley Rats” (Tao et al 2011) were pirated as
- Fig 3A from “Preparation and development of FeS2 Quantum Dots on SiO2 nanostructures immobilized in biopolymers and synthetic polymers as nanoparticles and nanofibers catalyst for antibiotic degradation” (Gao et al 2018).
- Fig 1A from “Synthesis and characterization of AgS decorated chitosan nanocomposites and chitosan nanofibers for removal of lincosamides antibiotic” (Gupta et al 2017).

Fig 1B from “Adsorption characteristics of graphene oxide as a solid adsorbent for aniline removal from aqueous solutions: Kinetics, thermodynamics and mechanism studies” (Fakhri 2017) was plundered from Fig 1B of “Biocompatibility of Graphene Oxide” (Wang et al 2011).

Most of Fakhri’s SEMs look genuine. He is unlikely to have access to an electron microscope, preferring to acquire them from as-yet undiscovered sources (the texts often specify a brand of microscope other than the one featured in the image-file metadata). But this one had no counterpart in the material world:


A small cadre of repeat authors lent their names to Fakhri’s willingness to hand-draw everything: frequent names include Vinod Kumar Gupta (36 collaborations); Shilpi Agarwal (21 collaborations); Sajjad Behrouz (8). However, most of Fakhri’s opuscules (especially later ones) acquire fresh co-authors, suggesting a high turn-over of collaborators… unless the co-authorship slots became purchased positions, for everything is for sale in the knacker’s yard of modern-day academia. Customers even include Dmitry Bokov, celebrated for the range of his talents and the size of his budget.
The incredible collaborations of Renaissance men and women
Nick Wise and Alexander Magazinov on the authorships-for-sale market on social media. Merely $700 for the 7th position on some paper way outside your expertise!
Gupta’s university were so proud of his participation in Fakhri’s inventiveness that they decided to promote one of the co-authored Fakhrications with a press release, which of course Eureka Alert were happy to accept.

But here we are most interested in the References sections of papers, which are often a bazaar in their own right, abounding with “Your Name Here” advertisements. When the MBAs took over university administration, their skill-sets did not stretch to assessing the quality of scholarship, so they opted for easily-quantified metrics to judge the value of researchers, like the number of times their papers are cited. So citations became a valuable, tradeable commodity, in accordance with the prophecy Campbell’s and Goodhart’s Laws. So our man is a player in the citation economy.
Fakhri exhibits a special fondness for citing niche papers from a stable of ‘Central Asian Journal of $SUBJECT Sci. Tech. Innov.’, from Central Asian Scientific Press (CAS) – a challenger in the academic-publishing area. Here “Central Asian” translates as Iran, for that country is an incubator for new publishers striving to break the US / European academic stranglehold (although the editor seems to be based in Tajikistan). Fakhri provides so much of the coverage of these upstart journals that I wonder if he is under some kind of gaes. I picked three CAS papers at random, and checked who’s citing them:

As Times Higher Education recently warned against Iranian citation cheaters:
“Highly cited researchers are also suspected of participating in so-called citation cartels or citation rings, whereby a group of researchers dishonestly cite each other’s work. In Iran, some even speak of publication and citation mafias, whose members not only trade citations but can even manipulate journals’ refereeing processes.“

Presumably there is a quid-pro-quo or even the other way around. Some sort of transactional element in bestowing these eleemosynary references upon random authors to enhance their academic performance indices.
These CAS papers are as good an entry-point as any to the enchanted world of Dimensions.ai and G**gle Scholar cross-reference links. One can start at any point and play Pong, bouncing between the citation buyers and providers. A single CAJ paper might be cited in dozens of later papers in bizarrely inappropriate contexts (as is inevitable given their niche topics)… perhaps the authors paid some broker for the bargain package. Check any one of those citation-slot sellers in turn, and you find scores of equally gratuitous references, including new papers mixed in with the familiar titles encountered already.
The process led me to heterogeneous catalysts, and to heterocyclic organic chemistry, and to Mosstafa Kazemi’s prodigious output of Review papers. This is a wonderworld in microcosm, and I felt inspired to devote a spreadsheet to Kazemi’s products. He is too modest to claim credit for the vast majority of them.
I urge Philip Page – Editor of Synthetic Communications. and professor at University of East Anglia in UK – to be a little more circumspect about the institutional affiliations and ontological status of authors, instead of accepting Gmail and Yahoo e-addresses as proof of their consensus-reality existence. Meet Alberto Sanchez-Mendoza of Complutense University of Madrid, who doesn’t exist, which didn’t stop him from being Corresponding Author on two paper-milled Review Articles in Synthetic Communications. helpfully piggy-backing several Chinese co-authors.

“Recent developments in the synthesis of N-aryl sulfonamides” (Wu et al 2021).
By “Review Articles” I really mean “template-driven citation delivery vehicles”. Both stagger under heavy cargos of spurious references to CAJ papers.

Otherwise, the only scholarly activity of the fictitious Sanchez-Mendoza was to co-write a paper with Mosstafa Kazemi (of Payame Noor University), in Journal of Medicinal and Chemical Sciences, an imprint of Sami Publishing Company or SPC.2

Perhaps Sanchez-Mendoza shares an office with Martyan Hanas – also at the Complutense University, equally fictitious. Hanas’ name is spelled “martynahanas.chem@yahoo.com” as his Corresponding Author e-address, leading Nick Wise to speculate that the inspiration is the real person Martyna Hanas. Nonexistence did not stop Martyan / Martyna from recruiting teams of Chinese authors to share credit for two Synthetic Communications Review Papers citation vehicles.


I also have doubts about the ontological status of Tanmay Mandal and Manisha Lakshman, from Chemistry Departments of the Universities of Delhi and Panjab respectively. Mandal’s identity appears to have been stolen from someone of the same name but at a different institution who was active 15 years ago.

“Ferrite nanoparticles: Catalysis in multicomponent reactions (MCR)” (Huang et al 2021)

“Catalytic application of copper iodide nanoparticles in organic synthesis” (Huang et al 2021).

As well as Synthetic Communications, they like to publish at Kazemi’s outlet, J.Synth.Chem.

“Fe3O4SiO2-Pip-SA nanocomposite: A novel and highly efficient reusable acidic catalyst for synthesis of rhodanine derivatives” (Lakshman 2022).
Lakshman co-authored a paper at J.Medicin.Chem.Sci. with Srinivasa Gupta. Otherwise, Gupta’s existence is only attested by papers in Synthetic Communications. and on Kazemi’s own journal-shaped spigot, so this is not dispositive evidence for the reality of either of them.

(CuFe2O4 NPs)” (Lakshman 2022);
“Magnetic Nano Cobalt Ferrite: An efficient recoverable catalyst for synthesis of 2,4,5-trisubstituted imidazoles” (Gupta & Lakshman 2021)


Ranjit Sharma at the Indian Institute of Technology (Madras) shares the same combination of traits: Chinese co-authors, a fondness for irrelevant citations of Central Asian Journals, and no discernable existence.

Ahmad Sajjadi might be less fictional. Opportunities to co-author his papers are for sale. Before earning a position at Islamic Azad University, he was affiliated to the Department of Chemistry at the Frankfurt University of Applied Science.
[LS: I tried to communicate with this university (which is not to be confused with the University of Frankfurt). They told me regarding Sajjadi (translated): “for data protection reasons, we are generally unable to pass on any personal data on former or current university members except those which can be found on our university website.” I interpreted this as a confirmation of Sajjadi’ current or past affiliation there. The university declared that can neither confirm nor deny that.]

You might well wonder whether the nebulous authorship of these papers inspires them to cite M. Kazemi, driven by enthusiasm rather than questions of relevance. Of course they do! In fact the entire dramatis personae seem to have crawled out of our man’s sock drawer, and the page-count of Synthetic Communications would be grievously impoverished without his contributions, whether direct or uncredited.
Though not a Synthetic Communicator, Mosstafa Kazemi made up for it by using his actual name to contribute the same paper to Synthetic Communications. again and again with slight variations in the title, the co-authors, and the payload of paid-for citations.
Things reach Peak Kazemi with a paper on Indium Bromide as catalyst, in which our man cites EVERYTHING: Central Asian Journals! Osteomyelitis! Membrane bioreactors! Vuggy carbonates! Bamboo residues!

Given the production-line profligacy of these reviews, it was not a great surprise to find that they are assembled from pre-existing components in a pleasing parallel to the synthesis methods of heterocyclic chemistry itself. Catalysis may have been involved. Textural overlaps ensue, and recycled citation plantations.


The seminal contributions of Rafael Luque and co-authors seem to have been a special inspiration. “Magnetically Recoverable Nanocatalysts” (Polshettiwar et al 2011) deserves a central position in the montage below.

Taylor & Francis really need to scrabble around down the backs of their staffroom sofas and find enough small change to pay for plagiarism-screening services. The alternative possibility is that T&F editors do indeed have access to plagiarism detection but Professor Page at Synthetic Communications prefers to ignore the warnings.
Before anyone accuses me of prejudicial hostility to Iranian authors or publishers, this is a good place to point out that from the citational perspective at least, Kazemi’s contributions to his own journal and to Journal of Medicinal and Chemical Sciences from SPC are irreproachable. They may be rearrangements or first drafts of reviews that have already appeared or will appear in Synthetic Communications, but there are no falsified references to Kazemi or anyone else. Credit where it’s due.
The incredible collaborations of Renaissance men and women
Nick Wise and Alexander Magazinov on the authorships-for-sale market on social media. Merely $700 for the 7th position on some paper way outside your expertise!
Too bored now to be arsed checking the output of K. Omri’s to see whom else he bought citations from. Suffice to say that Omri is the recipient of gratuitous, transactional references from five papers in the Fakhri oeuvre.
- “Facile colorimetric detection of Hg (II), photocatalytic and antibacterial efficiency based on silver-manganese disulfide/polyvinyl alcohol-chitosan nanocomposites” (Eskandari et al 2020).
- “High efficiency of Ag decorated CuMoO nanoparticles for heterogeneous photocatalytic activation, bactericidal system, and detection of glucose from blood sample” (Liu et al 2022).
- “Graphene oxides as support for the synthesis of nickel sulfide–indium oxide nanocomposites for photocatalytic, antibacterial and antioxidant performances” (Ashraf et al 2020).
- “Bio-photoelectrochemical degradation, and photocatalysis process by the fabrication of copper oxide/zinc cadmium sulfide heterojunction nanocomposites: Mechanism, microbial community and antifungal analysis” (Lei et al 2022).
A certain Chang-He Li, the doyen of machining-lubricant research, is a familiar name from earlier investigations of the citation-farming phenomenon. Li buys references from everyone. You don’t need to write about state-of-the-art milling technology (or the appropriate lubricants) in order to cite Li’s magisterial papers.

“Preparation of carbon dots-hematite quantum dots-loaded hydroxypropyl cellulose-chitosan nanocomposites for drug delivery, sunlight catalytic and antimicrobial application” (Chen et al 2021).
Coming back at last to S. Sudheer Khan, it turns out that he works with the same broker. There’s one case where Fakhri is the beneficiary of transactional citations from S. S. Khan. Mostly the citations flow in the other direction.
Khan has upgraded the fakery quality of his images to make them less glaringly synthetic or repetitive: his recent papers are above reproach. So our earlier efforts weren’t wasted; he took the opportunity to learn from the friendly advice offered in PubPeer threads (and echoed here at For Better Science) – spreadsheet here.
Fakhri did not choose to benefit from the advice. But in the last analysis, he has little incentive to make his forgeries more convincing. He is a Trusted Peer-Reviewer at Journal of Hydrogen Energy, because of course he is.
1. The three earliest Fakhrications (from 2013) have been been withdrawn, though, “at the request of the author(s) and/or editor”. Two from Arabian Journal of Chemistry, one from Journal of Industrial and Engineering Chemistry.
- “Adsorption behavior and mechanism of ammonium ion from aqueous solution onto nanoparticles zero valent iron” (Fakhri & Adami).
- “Removal of 4-chloro-2-nitrophenol from aqueous solution by adsorption on graphene oxide using a response surface methodological approach” (Fakhri).
- “Study of the adsorption of Heavy metals (Cd 2+ and Pb 2+) Ions on Calix[4]arene: Equilibrium and Kinetics Studies” (Zare et al).
2. Founded by, Directed-in-Chief by and named after Dr. Sami Sajjadifa.
CODA (not Fakhri-related)
Attentive readers should also remember the name of Afshin Davarpanah. As co-author, Afshin has 75 papers – often in MDPI journals, and often but not always on his specialty subjects of milling and drilling – that came to the attention of the virtue-signalling scolds who initiate PubPeer threads. Those co-authorships are sometimes purchased, leading to a succession of mismatched single-use collaborators, but what interests us here are the new heights of citational absurdity these papers attain: A single disposable sentence can be a Trojan Horse, smuggling scores or hundreds of absurdly irrelevant references into a paper… or if you are allergic to equine metaphors, a tugboat, towing a fully-laden citational container-ship into the harbour. Because MDPI.



“Petroleum industries tried to increase the oil production from underground hydrocarbon fields due to the global energy demand in various industries and crude oil and its components [1–16].”

After graduating from a small Welsh university, who do not boast of the connection, Afshin managed to join the editorial board of Elsevier‘s Energy Reports. That journal quickly became the Journal of Davarpanah Citations, though it was only the beginning of his career in the two-way trade in references. Notably, when other authors cite Davarpanah (whether those citations are extorted or purchased), they also tend to cite Kazemi. AND various Central Asian Journals of XXX.

CODA 2
(because the post wasn’t already long enough)
Pouya Ghamari Kargar from the University of Birjand has no obvious links to the authors encountered so far, but his favourite topics are nanomaterials and catalysis and such, and I am happy to include him as another data point towards the general conclusion that academic ethics in Iran have not benefited from various factors [*cough* theocratic gubblement & the consequent corruption]. He is a newcomer on the scene, only showing up in 2017, but six years are enough for 25 bogus papers so far. Inevitably there is a spreadsheet.

So here are some X-ray diffraction patterns, but someone rated their twisted sense of aesthetic graphutainment content as more important than scientific value, so they have been bedizened and bedecked with ersatz drop-shadows. This is Chaotic Evil chartjunk, and I have to ask, what kind of monster DOES this??!

Fig 2 from “Robust, highly active, and stable supported Co(ii) nanoparticles on magnetic cellulose nanofiber-functionalized for the multi-component reactions of piperidines and alcohol oxidation” (Kargar & Bagherzade 2021)
But it may be that the segments showing up repeatedly, variously arranged, within and between the diffractograms are even more important than the ornamentation… for the implication is that they were created with assistance from the digital equivalents of scissors and paste. One is left with the doleful suspicion that Kargar and his associates do not really have access to X-ray diffraction equipment.

Fig 4 from “Magnetic nanoparticles embedded in pectin‐based [sic] as an environmentally friendly recyclable nanocatalyst” (Kargar et al 2021).
Fe3O4 patterns are particularly repetitive, on account of a fondness for Fe3O4 nanoparticles as a substrate to be encrusted with other materials. The mountains skip like rams, and the little hills like lambs.

Hat-tip to Neodiprion demoides – one of the disembodied rogue AIs who contribute to PubPeer – for calling attention to all this. I should also credit Sylvain Bernès, who noticed Kargar’s fondness for mass-production of NMR diagrams based on the same baseline noise.

“Synthesis, characterization and cytotoxicity evaluation of a novel magnetic nanocomposite with iron oxide deposited on cellulose nanofibers with nickel (FeO@NFC@ONSM-Ni)” (Kargar et al 2021).

Cut-&-paste EDS spectra, though, are our man’s special forté. Credit, again, to Neodiprion. Five Six tours-de-force containing these variations on a theme were submitted in quick succession to RSC Advances, Cellulose, and Frontiers in Chemistry, as if Kargar was rattling the handles on various doors to see which journals were locked and which have a high tolerance for bullshit.
- “A Green Synthesis Strategy of Binuclear Catalyst for the C-C Cross-Coupling Reactions in the Aqueous Medium: Hiyama and Suzuki-Miyaura Reactions as Case Studies” (Frontiers in Chemistry, 2021).
- “The anchoring of a Cu(ii)-salophen complex on magnetic mesoporous cellulose nanofibers: green synthesis and an investigation of its catalytic role in tetrazole reactions through a facile one-pot route” (RSC Advances, 2021).
- “Robust, highly active, and stable supported Co(ii) nanoparticles on magnetic cellulose nanofiber-functionalized for the multi-component reactions of piperidines and alcohol oxidation” (RSC Advancees, 2021).
- “Synthesis, characterization and cytotoxicity evaluation of a novel magnetic nanocomposite with iron oxide deposited on cellulose nanofibers with nickel (FeO@NFC@ONSM-Ni)” (RSC Advances, 2021).
- “A novel water‐dispersible and magnetically recyclable nickel nanoparticles for the one‐pot reduction‐Schiff base condensation of nitroarenes in pure water” (Journal of the Chinese Chemical Society, 2021).
- “Nickel nanoparticles adorned on magnetized cellulose nanofibers: ultrasound-facilitated cross coupling reactions” (Cellulose, 2022).
We don’t know how many manuscripts were rejected but we can certainly see how many were accepted. In the cause of full disclosure, I should note that Frontiers editors have heeded the PubPeer critique and retracted one of those papers.
Most of these papers are collaborations with a longer-established author, Ghodsieh Bagherzade. Bagherzade’s Kargar-less papers are not 100% fabricated but they are not entirely honest either, especially when the topic is nanomaterials with bacteriocidal properties that are so strong that they need to be enhanced with Photoshop.
Fig 7 from “Quercetin as a Precursor for the Synthesis of Novel Nanoscale Cu (II) Complex as a Catalyst for Alcohol Oxidation with High Antibacterial Activity” (Moodi et al 2021).
All these accomplishments have been noticed in circles that count, and recently we find a number of familiar names buying or accepting co-authorship with Kargar. Rafael Luque and Christophe Len:
- “Cu/cellulose-modified magnetite nanocomposites as a highly active and selective catalyst for ultrasound-promoted aqueous O-arylation Ullmann and sp-sp2 Sonogashira cross-coupling reactions” (Kargar et al 2022).
- “Green and rapid and instrumental one-pot method for the synthesis of imidazolines having potential anti-SARS-CoV-2 main protease activity” (Azimi et al 2023). Authorship slots on this manuscript went up for auction in February 2023, prior to the appearance of the preprint version in April.

Rajender Varma.
- “Nickel nanoparticles adorned on magnetized cellulose nanofibers: ultrasound-facilitated cross coupling reactions” (Kargar et al 2022).
- “TiO2/g-C3N4/SO3H(IL): Unique Usage of Ionic Liquid-Based Sulfonic Acid as an Efficient Photocatalyst for Visible-Light-Driven Preparation of 5-HMF from Cellulose and Glucose” (Nayebi et al 2023).
I, Rajender Varma, Highly Cited Researcher
“I could not comprehend the situation where a university picks up on individuals with an extraordinary and sterling performance and basically destroy one of the top European institutions. ” – Raj Varma
If that is not an ascent to the giddy empyrean of a career culmination, I don’t know what is.

Donate to Smut Clyde!
If you liked Smut Clyde’s work, you can leave here a small tip of 10 NZD (USD 7). Or several of small tips, just increase the amount as you like (2x=NZD 20; 5x=NZD 50). Your donation will go straight to Smut Clyde’s beer fund
NZ$10.00









Great work by Smut Clyde once again.
“It came as no surprise that Dr Fakhri’s academic advancement was not impeded in the least by the number of PubPeer threads celebrating his creativity – none of which provoked retractions.”
98 PubPeer entries, just three withdrawn papers by the authors, no action by the publishers. And of course no ban of Ali “Fake” Fakhri and his gang mates.
Publishers CANNOT be for-profit entities. Utopian but obvious. Not that not-for-profit publishers would solve all the issues of scholarly publishing, but it would be a beginning.
LikeLike
You can imagine how frustrated I feel, that the number didn’t reach a round 100.
LikeLiked by 2 people
The actual meaning of “fakhri” is “glorious”, which seems appropriate for this level of fraud. While fakery may be a poor approach to gain respect in science, it is clear that in this fellow’s business there is no such thing as bad press. Maybe we should call it “Sci-Biz” to differentiate.
LikeLike
I think Dr Philip Page, emeritus professor at University of East Anglia and EiC of Synthetic Comms, will disagree with your assessment of Ali Fakhri.
LikeLike
Remember Dr.Mirkin and Spherical Nucleic Acids (SNA) such as Nanoflare technology? Only Dr R.Levy has the guts to call the B.S Mirkin continues to write reviews citing all his papers every year in ACS publications in the hopes of winning major prizes such as Lasker or Nobel.
https://en.wikipedia.org/wiki/Spherical_nucleic_acid
LikeLike
See also https://pubpeer.com/publications/3A1DC39CC805400D70A46F59A31B38
LikeLike